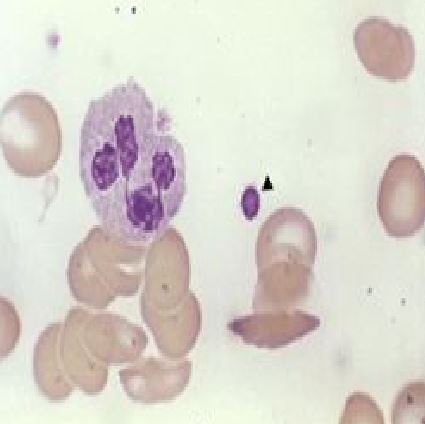
Ad: hem4.JPG
Gösterim: 9688
Boyut: 23.7 KB
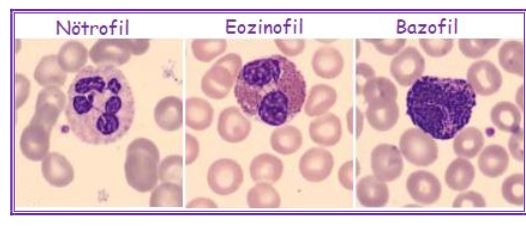
Ad: kanh5.JPG
Gösterim: 13955
Boyut: 27.8 KB
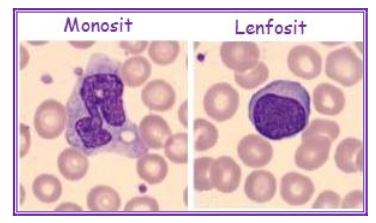
Ad: kanh6.JPG
Gösterim: 10280
Boyut: 21.5 KB

Kan Hücreleri ve Kan Hücrelerinin Görevleri
İnsan kanı plazma denen sarımsı renkte bir sıvı ile bu sıvının içinde yüzen kan hücrelerinden oluşur. Plazmanın yaklaşık yüzde 90'ı su, geri kalan bölümü suda erimiş maddelerdir:
Ancak bir mikroskopla görülebilen alyuvarlar, tıpkı bir tavla pulu gibi kenarları daha kalın, ortası hafifçe çukur olan yuvarlak ve yassı, çekirdeksiz hücrelerdir. Bir alyuvarın yaklaşık üçte biri, demirli bir bileşik olan ve kana kırmızı rengini veren hemoglobin''den oluşur. Öbür omurgalıların alyuvarlarında da aynı bileşik bulunduğu için hepsinin kanı kırmızıdır. Oysa yumuşakçaların kanındaki kimyasal madde plazmaya mavi, halkalısolucanlarda ise yeşil renk verir.
Ama hemoglobinin asıl görevi kanı renklendirmek değil dokulara oksijen taşımaktır. Kan akciğerlerdeki kılcal damarların içinde akarken, solunum yoluyla akciğerlere dolmuş olan havanın oksijeni kana geçerek alyuvarlardaki hemoglobine bağlanır. Daha sonra kan bütün vücudu dolaşırken de oksijen hemoglobinden ayrılarak hücrelere geçer.
Alyuvarlar kemik iliğinde yapılır ve her birinin yaklaşık 120 gün kadar ömrü vardır. Ömrünü tamamlayan yaşlı alyuvarlar parçalanarak yok olurken bunların yerini kemik iliğinde yapılan yeni hücreler alır. Vücuttaki alyuvarların sayısı o kadar çoktur ki, ölenlerin yerini almak üzere dakikada 2 milyon kadar alyuvar kana karışır.
Akyuvarlar alyuvarlardan daha büyük, ama sayıca daha azdır. İnsan kanında ortalama 500 alyuvara karşılık bir tek akyuvar bulunur. Ama vücuda bir mikrop ya da yabancı bir madde girdiğinde akyuvarların sayısı hızla artar. Çünkü bunlar vücudu savunmakla görevli olan koruyucu hücrelerdir. Üstelik bu kan hücreleri alyuvarlar gibi her zaman kan plazmasının içinde yüzmek zorunda da değildir; kılcal damarların duvarlarından dışarı çıkıp dokulara girebilir ve mikroplarla savaşmak üzere vücudun her yanına ulaşabilir.
Çekirdekli kan hücreleri olan akyuvarların birbirinden farklı yapıda beş değişik tipi, bunlardan çoğunun da ayrı bir savunma yöntemi vardır. Hastalık yapıcı bakteri ya da virüsler kana girdiği anda akyuvarlar çoğalır ve bu mikrobu yok etmek üzere harekete geçer. İçlerinden bir bölümü bakterinin çevresini kendi hücresiyle sarar ve içine aldığı mikrobu yavaş yavaş sindirir. Bu olaya fagositoz denir. Bazı akyuvarlar ise mikroplarla doğrudan savaşmak yerine antikor denen maddeleri üretir. Bu kimyasal madde zararlı hücreleri bulur ve gidip üzerine kenetlenerek ya etkisiz duruma getirir ya da yok eder. Bu savaşta genellikle çok sayıda akyuvar da ölür ve hepsinin kalıntıları birbirine karışarak irin denen kirli sarı renkte, yapışkan bir sıvı halinde yaralardan dışarı atılır.
Erişkin bir insanın vücudunda 5-6 litre kadar kan vardır ve sağlıklı bir insan 1-2 litre kan kaybettiğinde vücut bu eksiği kısa sürede giderebilir. Ama ağır kanamalarda insan kan kaybından ölebilir.
Pıhtılaşmış kan artık eskisi gibi kırmızı renkli, homojen bir sıvı değildir. Fibrinojen ile kan hücreleri birleşerek koyu renkli bir pıhtı kütlesi halinde topaklaşmış, geride açık sarı renkli bir sıvı kalmıştır. İçinde kan hücreleri ve pıhtılaştırıcı plazma proteinleri olmayan bu sıvıya serum denir. Doktorlar insanları bazı bulaşıcı hastalıklardan korumak için atların kan serumundan yararlanırlar. Ata belirli bir hastalığın mikrobu verildiğinde hayvanın kanında antikorlar oluşur ve bu bağışık serum insana şırınga edildiğinde o hastalığa karşı bağışıklık kazandırır. Hücrelere oksijen ve besin taşımak, atıkları uzaklaştırmak ve vücudu mikroplara ya da zararlı maddelere karşı savunmak kanın görevlerinden yalnızca bir bölümüdür. Bunların dışında, iç salgıbezlerince üretilen hormonları dokulara taşıyarak vücut işlevlerinin düzenlenmesine ve iç dengenin korunmasına yardımcı olur. Ayrıca, kalorifer borularında dolaşan suyun yapının her yanını ısıtması gibi, kan da kalp ve karaciğer gibi enerji üreten organlardan aldığı ısıyı vücudun öbür bölümlerine taşıyarak bütün vücudun hep aynı sıcaklıkta kalmasını sağlar.
İnsan kanı plazma denen sarımsı renkte bir sıvı ile bu sıvının içinde yüzen kan hücrelerinden oluşur. Plazmanın yaklaşık yüzde 90'ı su, geri kalan bölümü suda erimiş maddelerdir:
- Albümin, fibrinojen ve globülinler gibi plazma proteinleri
- Glikoz, aminoasitler, yağlar, mineral tuzları ve vitaminler gibi besin maddeleri
- Karbon dioksit ve üre gibi atık maddeler
- Hormonlar
- Antikorlar
Sponsorlu Bağlantılar
- Alyuvarlar (Eritrositler)
- Akyuvarlar (Lökositler)
- Trombositler (Kan pulcukları)
Ancak bir mikroskopla görülebilen alyuvarlar, tıpkı bir tavla pulu gibi kenarları daha kalın, ortası hafifçe çukur olan yuvarlak ve yassı, çekirdeksiz hücrelerdir. Bir alyuvarın yaklaşık üçte biri, demirli bir bileşik olan ve kana kırmızı rengini veren hemoglobin''den oluşur. Öbür omurgalıların alyuvarlarında da aynı bileşik bulunduğu için hepsinin kanı kırmızıdır. Oysa yumuşakçaların kanındaki kimyasal madde plazmaya mavi, halkalısolucanlarda ise yeşil renk verir.
Ama hemoglobinin asıl görevi kanı renklendirmek değil dokulara oksijen taşımaktır. Kan akciğerlerdeki kılcal damarların içinde akarken, solunum yoluyla akciğerlere dolmuş olan havanın oksijeni kana geçerek alyuvarlardaki hemoglobine bağlanır. Daha sonra kan bütün vücudu dolaşırken de oksijen hemoglobinden ayrılarak hücrelere geçer.
Alyuvarlar kemik iliğinde yapılır ve her birinin yaklaşık 120 gün kadar ömrü vardır. Ömrünü tamamlayan yaşlı alyuvarlar parçalanarak yok olurken bunların yerini kemik iliğinde yapılan yeni hücreler alır. Vücuttaki alyuvarların sayısı o kadar çoktur ki, ölenlerin yerini almak üzere dakikada 2 milyon kadar alyuvar kana karışır.
Akyuvarlar alyuvarlardan daha büyük, ama sayıca daha azdır. İnsan kanında ortalama 500 alyuvara karşılık bir tek akyuvar bulunur. Ama vücuda bir mikrop ya da yabancı bir madde girdiğinde akyuvarların sayısı hızla artar. Çünkü bunlar vücudu savunmakla görevli olan koruyucu hücrelerdir. Üstelik bu kan hücreleri alyuvarlar gibi her zaman kan plazmasının içinde yüzmek zorunda da değildir; kılcal damarların duvarlarından dışarı çıkıp dokulara girebilir ve mikroplarla savaşmak üzere vücudun her yanına ulaşabilir.
Çekirdekli kan hücreleri olan akyuvarların birbirinden farklı yapıda beş değişik tipi, bunlardan çoğunun da ayrı bir savunma yöntemi vardır. Hastalık yapıcı bakteri ya da virüsler kana girdiği anda akyuvarlar çoğalır ve bu mikrobu yok etmek üzere harekete geçer. İçlerinden bir bölümü bakterinin çevresini kendi hücresiyle sarar ve içine aldığı mikrobu yavaş yavaş sindirir. Bu olaya fagositoz denir. Bazı akyuvarlar ise mikroplarla doğrudan savaşmak yerine antikor denen maddeleri üretir. Bu kimyasal madde zararlı hücreleri bulur ve gidip üzerine kenetlenerek ya etkisiz duruma getirir ya da yok eder. Bu savaşta genellikle çok sayıda akyuvar da ölür ve hepsinin kalıntıları birbirine karışarak irin denen kirli sarı renkte, yapışkan bir sıvı halinde yaralardan dışarı atılır.
Akyuvarların vücuttaki yapım yerleri kemik iliği, dalak ve lenf düğümleridir. Nitekim vücudun savunmasında ve bağışıklık sisteminde temel rol oynayan lenf sıvısında hücre olarak yalnızca akyuvarlar bulunur.
Trombositler hem akyuvarlardan, hem alyuvarlardan çok daha küçüktür; ama kanın pıhtılaşmasını sağlamak gibi çok önemli bir görevleri vardır. Deride bir çizik ya da kesik olduğu zaman, damarların duvarlarındaki bu açıklıktan sızan kan dışarı akmaya başlar. Bu durumda, kan plazmasındaki fibrinojen maddesi trombositlerin yardımıyla pıhtı oluşturmak üzere harekete geçer. Fibrinojen damarın dışına çıkarak havayla karşılaştığı anda küçük, yapışkan iplikçiklere dönüşür ve başta trombositler olmak üzere bütün kan hücrelerini birbirine bağlayarak süngersi bir kütle oluşturur. Pıhtı denen bu madde damardaki kesiği bir tıkaç gibi kapatarak kanamayı engeller.Erişkin bir insanın vücudunda 5-6 litre kadar kan vardır ve sağlıklı bir insan 1-2 litre kan kaybettiğinde vücut bu eksiği kısa sürede giderebilir. Ama ağır kanamalarda insan kan kaybından ölebilir.
Pıhtılaşmış kan artık eskisi gibi kırmızı renkli, homojen bir sıvı değildir. Fibrinojen ile kan hücreleri birleşerek koyu renkli bir pıhtı kütlesi halinde topaklaşmış, geride açık sarı renkli bir sıvı kalmıştır. İçinde kan hücreleri ve pıhtılaştırıcı plazma proteinleri olmayan bu sıvıya serum denir. Doktorlar insanları bazı bulaşıcı hastalıklardan korumak için atların kan serumundan yararlanırlar. Ata belirli bir hastalığın mikrobu verildiğinde hayvanın kanında antikorlar oluşur ve bu bağışık serum insana şırınga edildiğinde o hastalığa karşı bağışıklık kazandırır. Hücrelere oksijen ve besin taşımak, atıkları uzaklaştırmak ve vücudu mikroplara ya da zararlı maddelere karşı savunmak kanın görevlerinden yalnızca bir bölümüdür. Bunların dışında, iç salgıbezlerince üretilen hormonları dokulara taşıyarak vücut işlevlerinin düzenlenmesine ve iç dengenin korunmasına yardımcı olur. Ayrıca, kalorifer borularında dolaşan suyun yapının her yanını ısıtması gibi, kan da kalp ve karaciğer gibi enerji üreten organlardan aldığı ısıyı vücudun öbür bölümlerine taşıyarak bütün vücudun hep aynı sıcaklıkta kalmasını sağlar.
MsXLabs.org & Temel Britannica
Son düzenleyen Safi; 20 Haziran 2016 23:34
Tanrı varsa eğer, ruhumu kutsasın... Ruhum varsa eğer!

Kan Hücreleri Nedir - Kan Hücrelerinin Yapısı ve Görevleri